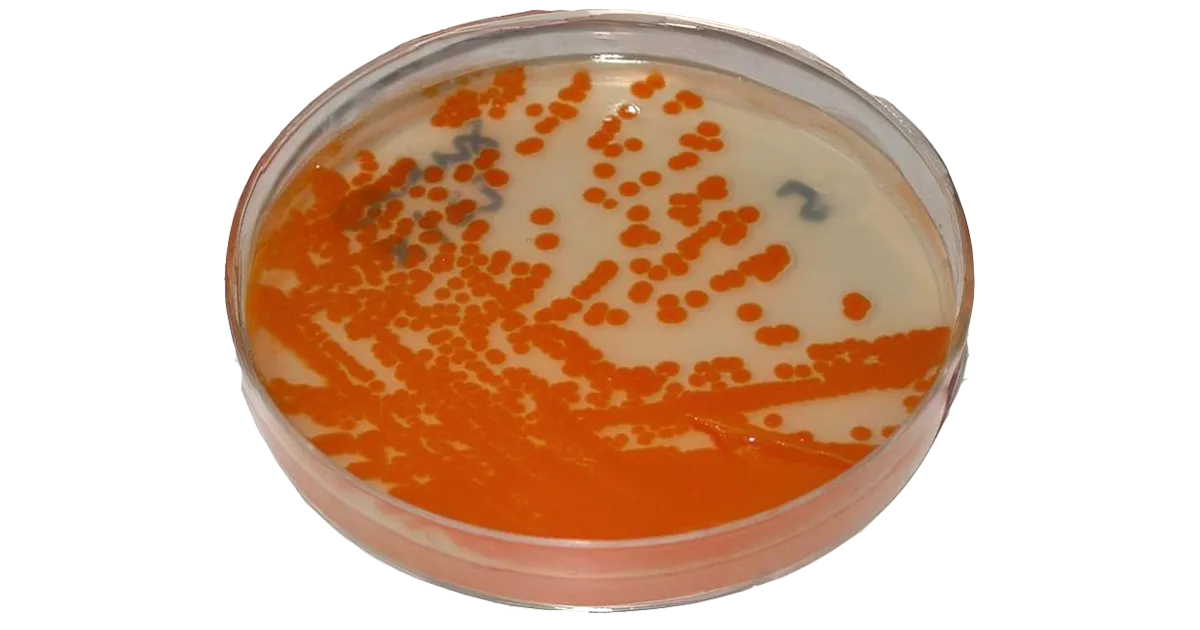
Bactéria comum em gestantes está circulando mais e com maior resistência aos antibióticos

Bactéria comum em gestantes está circulando mais e com maior resistência aos antibióticos
Estudo com o estreptococo do grupo B (GBS) revela grande variabilidade genética entre bactérias, o que pode aumentar o risco de infecções
Por Da Redação

Estudo com o estreptococo do grupo B (GBS) revela grande variabilidade genética entre bactérias, o que pode aumentar o risco de infecções
Por Da Redação